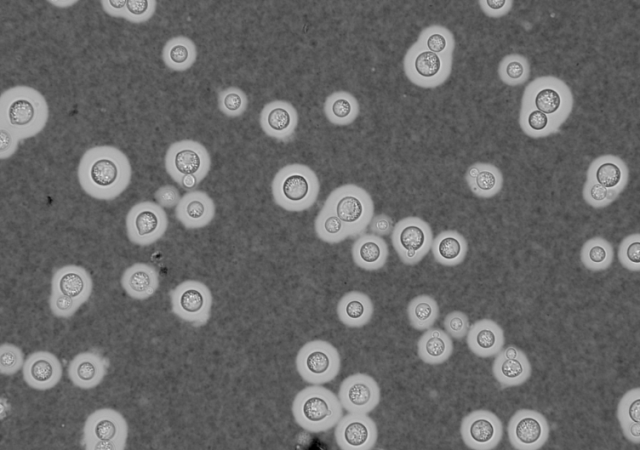
india ink fungal staining technique - Negative staining of Cryptococcal capsulesImage source:Doering lab

Fungal staining technique helps in clear visualization for studying the morphological characteristics of fungi that aid in detecting and identifying fungi, thus playing a crucial role in diagnosing fungal infections. Fungal staining techniques can be broadly categorized as wet mount preparation and differential staining.
A wet mount is a fungal staining technique performed by suspending the specimen in the reagent solution and observing it in the microscope. Potassium hydroxide (KOH) wet mount, lactophenol cotton blue (LPCB) stain, India ink stain or Nigrosin stain, calcofluor white stain, PHOL stain, neutral red stain, and diazonium blue b (DBB) stain are some of the wet mount technique for identifying fungus.
Differential staining is a fungal staining technique that uses more than one stain. The color contrast aids in identification of the organisms. The different types of differential stains used for fungus identification are hematoxylin and eosin (HE) stain, May-Grunwald Giemsa (MGG) stain, diff-quick stain, periodic acid-Schiff (PAS) stain, Gridley’s fungal stain, Gromori’s methenamine silver stain, Mayer’s mucicarmine stain, Masson-Fontana (MF) stain, Schmorl’s melanin stain, Toluidine blue O stain, acridine orange stain, and fluorescent-antibody stain. Gram stain and modified acid-fast stain are also useful to identify fungal isolates.
Potassium Hydroxide (KOH) Mount

Potassium hydroxide (KOH) is a strong alkali, and it digests and dissolves the tissue material in the skin, hair, nail, or sputum sample for the clear observation of fungi. Depending on the clinical specimens, the potassium hydroxide wet mount can be prepared on a slide or tube.
It is the primary screening method for identifying fungal elements in clinical samples. KOH wet mount helps to diagnose dermatophytosis (ringworm), mucormycosis, chromoblastomycosis, Blastomyces dermatitidisinfection, etc.
Read more:KOH wet mount preparation.
Lactophenol Cotton Blue

Lactophenol cotton blue (LPCB) wet mount preparation is a widely used routine laboratory technique. Phenol acts as the disinfectant and kills the fungus, lactic acid preserves the fungal morphology, glycerol prevents drying, and cotton blue stains the outer wall of the fungus. It is performed in two ways: standard tease mount and cellophane tape.
LPCB wet mount detects and identifies the fungus from the culture medium. LPCB stains the fungal elements in blue color.
Read more:LPCB wet mount
Gram stain
Gram staining is the differential method for detecting bacteria, but it also helps identify fungi. Fungi appear as Gram-positive (purple color). While examining clinical specimens, detecting fungal elements (hyphae, yeasts, or mycelia) helps us diagnose fungal infections.
There are two modifications of the Gram stain for staining the tissues.
- Weigert’s modification of the Gram stain helps to identify Pneumocystiscysts.
- Brown and Brenn’s modification of the Gram stain is used to identify Nocardia, *Actinomyces,*and Microsporidiumspp.
India Ink and Nigrosin Stain
India Ink and Nigrosin stain are the acidic dyes used in negative staining. Either India ink or Nigrosin stain helps to stain capsules. Nigrosin stain is preferred over India stain because it can last more than one year, and no carbon particles will appear in the solution.
These stains detect capsule-forming fungi such as Cryptococcus neoformans which causes cryptococcal meningitis. The capsule appears as a clear halo against the dark background.
Calcofluor White Stain

Calcofluor white stain is the fluorescent dye that stains the chitin present in the cell wall of fungi. It is a water-soluble, colorless dye and a fluorescent whitener. It fluoresces light-blue in color when exposed to UV light in a fluorescent microscope.
Calcofluor white staining is used to detect hyphae, pseudohyphae, and yeast. Under the fluorescent microscope observation, the fungus fluoresces green. It also helps to detect non-culturable fungi like Pneumocystis jirovecii.
Hematoxylin and Eosin Stain

Hematoxylin stains the cell’s nuclei in blue, and eosin stains the cytoplasm in pink. H and E stain helps to differentiate the nuclear and cytoplasmic parts. Hematoxylin stains the nuclear components like the heterochromatin and nucleoli. Eosin stains the cytoplasmic components like collagen and elastic fiber, muscle fibers, and red blood cells.
Hematoxylin and Eosin stain is used to examine the frozen sections of tissues, fine needle aspirates, and paraffin fixed embedded tissue. It can be useful in examining the biopsy sample when cancer is suspected. H and E stain helps visualize hyphae, yeast cells (nucleus), the double refractive cell wall of Blastomyces,and the spherule ofCoccidioides.
May-Grunwald Giemsa Stain
May Grunwald-Giemsa stain is made from two stains, May Grunwald stain, and Giemsa stain. May Grunwald stain consists of methylene blue and eosin. Giemsa stain consists of methylene blue, eosin, and azure B.
May-Grunwald Giemsa stain detects theHistoplasma capsulatum in the peripheral blood smear. This staining technique stains the blood and bone marrow smears. Differential counting of the blood cells can be one. It helps to visualize the chromosomes and identify the mast cells.
Diff-Quik Stain
Diff-Quick Stain consists of fixative, stain solution I, and stain solution II. This is a ‘dip’ stain and uses the Coplin jars. It is based on the modification of the Wright Giemsa stain. Diff-Quick stain is better than Wright Giemsa Stain because the 4 min procedure completes in just 15 seconds.
Diff-Quick stain is useful for rapid staining and differentiation of the smears, like blood and vaginal smears. Fungi appear in as dark blue color.
Periodic Acid-Schiff Stain

The periodic acid-Schiff (PAS) is a staining technique that identifies the presence of glycogen, polysaccharides, and mucin in the tissue. These tissue sections may be formalin-fixed, paraffin-embedded, or frozen. PAS stains the nuclei blue and fungi in deep pink or magenta color. Â
PAS stain is useful for identifying Cryptococcus neoformans, Histoplasma capsulatum, Aspergillus fumigatus, and Blastomycesin tissue samples because their cell walls and capsules contain a significant amount of carbohydrates.
Gridley’s Fungal Stain
Gridley’s Fungal stain is like the PAS stain but uses chromic acid as the oxidizing agent. This technique combines Bauer, Schiff, and aldehyde fuchsin techniques.
Gridley’s fungal stains the fixed tissue sections. It stains the mycelia and conidia in deep purple color and elastic tissue and mucin background in the yellow color. It does not stain the actinomycetes.
Gomoris Methenenamine Silver Stain
Gomori’s methenamine silver stain (GMS) is useful for the demonstration of the polysaccharide content of the fungus in tissue sections. The most widely used stain is Grocott’s modification of the GMS stain, known as Grocott’s Gomoris Methenenamine Silver Stain. GMS stain can stain degenerated and non-viable fungi too. It stains the fungi and bacteria black, mucopolysaccharide dark grey, and tissue pale green.
GMS stain identifies the *Pneumocystis jiroveci,*which causes the pneumocystosis.
Mayer’s Mucicarmine Stain
Mayer’s Mucicarmine stains the mucin, a secretion produced by different epithelial cells. Epithelial cells produce mucin in excess amounts during carcinoma or in some inflammations.
Mayer’s Mucicarmine stain detects the Cryptococcusand Rhinosporidiumspp. in tissue. It stains the Cryptococcus spp. deep rose red, nuclei black, and the tissue in yellow color. In the case of rhinosporidiosis, mucicarmine stain the sporangium and endospores.
Masson-Fontana Stain
Masson-Fontana (MF) stain detects a cell’s argentaffin granules and melanin. It is useful for examining the frozen or paraffin-embedded tissue sections. Melanin is the brown, black pigment that is also present in the human body’s hair, skin, retina, and iris. Argentaffin granules are present in carcinoid tumors. Mosson-Fontana stains the melanin and argentaffin granules in black color and nuclei in red.
Masson-Fontana (MF) stain detects melanin-containing dematiaceous (phaeoid) fungi like Curvularia lunataand Bipolaris hawaiiensisin tissue.
Schmorl’s Melanin Stain
Schmorl’s Melanin stain is the melanin-based staining method that detects the presence of the reducing substances in the tissues like melanin, keratin, keratohyalin, etc. Melanin is present in the cell wall of the dematiaceous (phaeoid) fungi. This technique uses the reducing properties of melanin to stain granules in blue-green color. It stains the nuclei in pinkish-red and cytoplasm a pale-pink color.
Schmorl’s melanin stain is useful for diagnosing phaeohyphomycosis in tissue biopsy.
Toluidine Blue O Stain
Toluidine Blue is a metachromatic dye. It stains the frozen tissue section rapidly in about 10-20 seconds. Toluidine blue O stain stains the cysts of Pneumocystis jirovecii as reddish blue or dark purple against a light blue background. It detects only the cyst form, not the trophozoite form.
Toluidine blue O stain is useful for detecting the Pneumocystis jirovecii in the lung biopsy and bronchoalveolar lavage (BAL) fluid.
Acridine Orange Stain
Acridine orange stain is the fluorochrome dye that binds the cells’ nucleic acids. When fungi are stained with the acridine dye and viewed under ultraviolet light, RNA fluoresces orange-red and the DNA as green. The differential staining of the DNA and RNA requires a pH of 6. Acridine orange stains the human epithelial cell, inflammatory cell, and background debris, which appear pale green to yellow color.
Acridine orange stain is useful in demonstrating the fungi in tissue sections and smear rapidly. It is also useful for identifying the fungus Aspergillusspp., Blastomyces dermatitidis, Candida albicans, Coccidioides immitis,Cryptococcus neoformans, Histoplasma capsulatum, and Rhinosporidium seeberiin tissue sections.
Fluorescent-Antibody Stain
Fluorescent-antibody stain is an antigen detection test in which the antibody is tagged with the fluorochrome. It detects fungal antigens in pus, blood, cerebrospinal, and paraffin sections of formalin-fixed tissues.
The fluorescent antibody is useful in detecting Sporothrix schenckii,Aspergillusspp., Blastomyces dermatitidis, Cocciodioides immitis, Cryptococcus neoformans, *Histoplasma capsulatum,*etc.
PHOL Stain
PHOL stain is derived from the scientist’s name Pal, Hasegawa, Ono, and Lee. The LPCB and PHOL have similar functions but differ in the stain’s composition. In PHOL stain, formalin replaces phenol, and methylene blue replaces cotton blue.
PHOL stain is useful in examining the fungal isolates and Prototheca species.
Neutral Red Stain
Neutral Red Stain is a water-soluble dye. It can pass through the intact plasma membrane and the lysosome of viable cells can store it. When cell membrane and lysosomes are damaged, dye uptake decreases.
Neutral Red Stain is used to differentiate the viable and non-viable fungus. The microscopic observation and the fungal culture are done to diagnose dermatophytosis. Sometimes fungus can be observed during direct microscopic observation, but it may not grow in the culture medium. In such cases, a neutral stain helps to know if the fungus is viable because it will stain the viable cell red and won’t stain the non-viable cell.
Diazonium Blue B stain
Diazonium Blue B stain (DBB) is useful in differentiating the species of two genera of fungi, basidiomycetes, and ascomycetes. DBB positive will stain dark-red or violet red, and DBB negative won’t stain.
Diazonium Blue B stain differentiates Trichosporon spp (basidiomycetes) from the Geotrichumspp. (ascomycetes). Trichosporon spp. is DBB positive and Geotrichum spp. is DBB negative.
References
- Chick, E. W., & Chick, E. W. (1961). Acridine Orange Fluorescent Stain for Fungi. Archives of Dermatology, 83(2), 305–309. https://doi.org/10.1001/archderm.1961.01580080135015
- Ebenye, C. M. (2012). A case of disseminated histoplasmosis detected in peripheral blood smear staining revealing AIDS at terminal phase in a female patient from Cameroon. Case Reports in Medicine, 2012. https://doi.org/10.1155/2012/215207
- Gridley, M. F. (1953). A Stain for Fungi in Tissue Sections. American Journal of Clinical Pathology, 23(3_ts), 303–307. https://doi.org/10.1093/ajcp/23.3_ts.303
- Haque, A. (2010). Special Stains Use in Fungal Infections. Connection, 187–194. http://www.dako.com/us/28829_connection_14.pdf#page=187
- Kaplan, W. (1973). Direct fluorescent antibody tests for the diagnosis of mycotic diseases. Annals of Clinical Laboratory Science, 3(1), 25–29.
- KAPLAN, W., & IVENS, M. S. (1960). Fluorescent antibody staining of Sporotrichum schenckii in cultures and clinical materials. The Journal of Investigative Dermatology, 35(3), 151–159. https://doi.org/10.1038/jid.1960.99
- Lowrey, T. (1986). A modified sulfation-toluidine blue technique for the demonstration of fungi in tissue sections: A brief report. Journal of Histotechnology, 9(1), 23–24. https://doi.org/10.1179/his.1986.9.1.23
- Naka, W., Hanyaku, H., Tajima, S., Harada, T., & Nishikawa, T. (1992). Application of Neutral Red Staining for Evaluation of the Viability of Dermatophytes in Human Skin Scales. Nippon Ishinkin Gakkai Zasshi, 33(2), 207–211. https://doi.org/10.3314/jjmm.33.207
- Piaton, E., Fabre, M., Goubin-Versini, I., Bretz-Grenier, M. F., Courtade-Saïdi, M., Vincent, S., Belleannée, G., Thivolet, F., Boutonnat, J., Debaque, H., Fleury-Feith, J., Vielh, P., Egelé, C., Bellocq, J. P., Michiels, J. F., & Cochand-Priollet, B. (2016). Guidelines for May-Grünwald–Giemsa staining in haematology and non-gynaecological cytopathology: recommendations of the French Society of Clinical Cytology (SFCC) and of the French Association for Quality Assurance in Anatomic and Cytologic Pathology (AFAQAP). Cytopathology, 27(5), 359–368. https://doi.org/10.1111/cyt.12323
- Schnadig, V. J., & Woods, G. L. (2009). Histopathology of fungal infections. Clinical Mycology, 79–108. https://doi.org/10.1016/B978-1-4160-5680-5.00005-0
- Walker, D. H., & McGinnis, M. R. (2014). Diseases Caused by Fungi. In Pathobiology of Human Disease: A Dynamic Encyclopedia of Disease Mechanisms. Elsevier Inc. https://doi.org/10.1016/B978-0-12-386456-7.01710-X
- West, K. L., Proia, A. D., & Puri, P. K. (2017). Fontana-Masson stain in fungal infections. Journal of the American Academy of Dermatology, 77(6), 1119–1125. https://doi.org/10.1016/j.jaad.2017.02.052